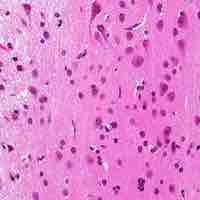
Thumbnail

Chapter 10
Overview of the Nervous System
By Boundless
The nervous system is a network of cells called neurons that coordinate actions and transmit signals between different parts of the body.

The primary function of the nervous system is to coordinate and control the various functions of our body.

The CNS includes the brain and spinal cord, while the PNS is a network of nerves linking the body to the brain and spinal cord.

Glia (named from the Greek for "glue") helps in supporting and scaffolding neurons, while performing many unique functions.

The two kinds of glia cells in the PNS, schwann cells and satellite cells, each have unique functions.

A nucleus can either by a relatively compact collection of neurons or a distinctly identifiable group of neurons spread over a large area.
A bundle of axons is called a nerve in the peripheral nervous system and a tract in the central nervous system.
The basic pattern of the CNS is a central cavity surrounded by gray matter made up of neuronal cell bodies external to which is the white matter which is made up of myelinated axons.

When a neuron is stimulated, an electrical impulse is generated and conducted along the length of its axon. This process, called action potential, underlies many nervous system functions.

Ion channels are membrane proteins that allow ions to travel into or out of a cell.

The potential difference in a resting neuron is called the resting membrane potential.

The membrane potential allows a cell to function as a battery, providing electrical power to activities within the cell and between cells.

Neurons typically send signals over long distances by generating and propagating action potentials over excitable axonal membrane.

A synapse is a structural junction that mediates information transfer from one neuron to the next or from one neuron to an effector cell as in muscle or gland.

Postsynaptic potentials are excitatory or inhibitory changes in the graded membrane potential in the postsynaptic terminal of a chemical synapse.

Synaptic transmission is a chemical event which is involved in the transmission of the impulse via release, diffusion, receptor binding of neurotransmitter molecules and unidirectional communication between neurons.
Neurotransmitters are endogenous chemicals that transmit signals from a neuron to a target cell across a synapse.
Although both ionotropic and metabotropic receptors are activated by neurotransmitters, ionotropic receptors are channel-linked while metabotropic receptors initiate a cascade of molecules via G-proteins.

Serial memory processing compares a memory to a target stimulus, while parallel processing carries out multiple operations simultaneously.

